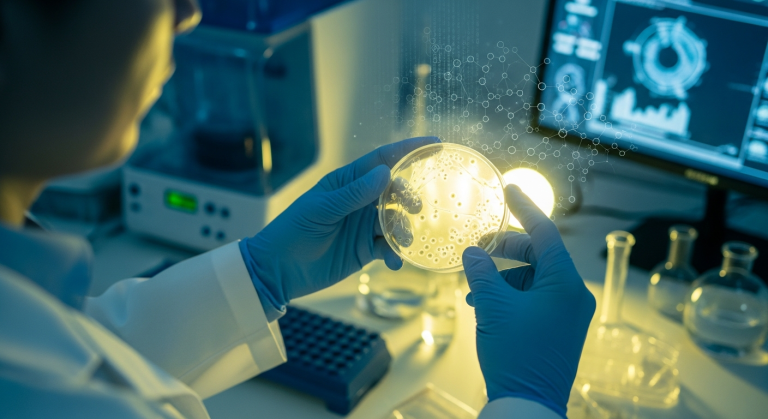
UAE's ADSCC Unveils Innovative Cancer Treatment Using TILs

Discover why Premanand Ji Maharaj advises against hot water baths. Explore traditional wisdom and its impact on...
Health
Delhi grapples with alarming air pollution levels, with the Air Quality Index (AQI) exceeding 350. Dense smog...
Discover the best winter diet secrets! Learn about 4 essential foods to combat fatigue, boost well-being, and...
Himachal Pradesh government invests ₹213.75 crore to enhance healthcare facilities, including advanced diagnostic equipment and improved treatment...
ADSCC in Abu Dhabi introduces innovative TIL therapy for cancer, a groundbreaking immunotherapy using patient's own cells....
Discover Premanand Ji Maharaj's wisdom: Embrace action, release worry! Learn his teachings on devotion, faith, and achieving...
Discover the subtle signs of silent inflammation after 40. Learn about fatigue, weight gain, brain fog, and...
Enjoy the winter with Mix Veg Suji Pakoda! This recipe blends suji (semolina) and fresh veggies for...
Combat winter dryness and dullness with these simple skincare tips! Discover how to keep your skin healthy,...
Discover key health risks men face and proactive steps for prevention. Learn about early detection, healthy lifestyle...